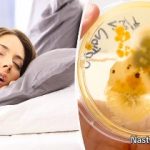

Σε εκδήλωση γνωστής εταιρείας που έγινε στη Μύκονο με καλεσμένο τον Τζώρτζ Κλούνεϊ βρέθηκε και ο Δήμαρχος του νησιού Κωνσταντίνος Κουκάς.
Λείπει ο Μάρτης από την Σαρακοστή;
- Ο ίδιος είχε μια ολιγόλεπτη κουβέντα με τον ξένο σταρ, ενώ ο ηθοποιός έδειξε να τον συμπαθεί ιδιαίτερα καθώς ήταν πολύ φιλικός μαζί του.
Δείτε εικόνες μέσα από το πάρτι. Έρχονται και εκλογές όποτε…

GIPHY App Key not set. Please check settings